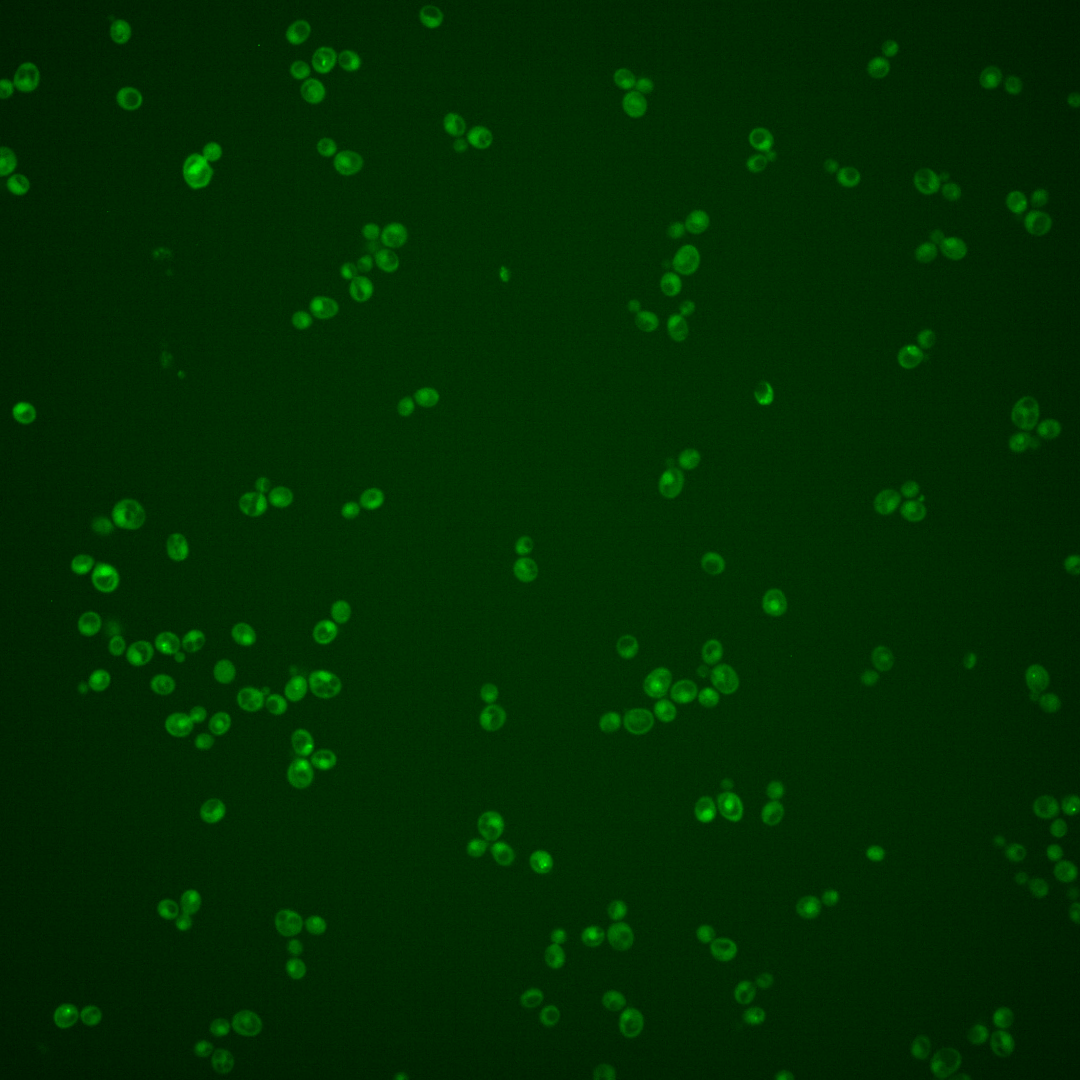
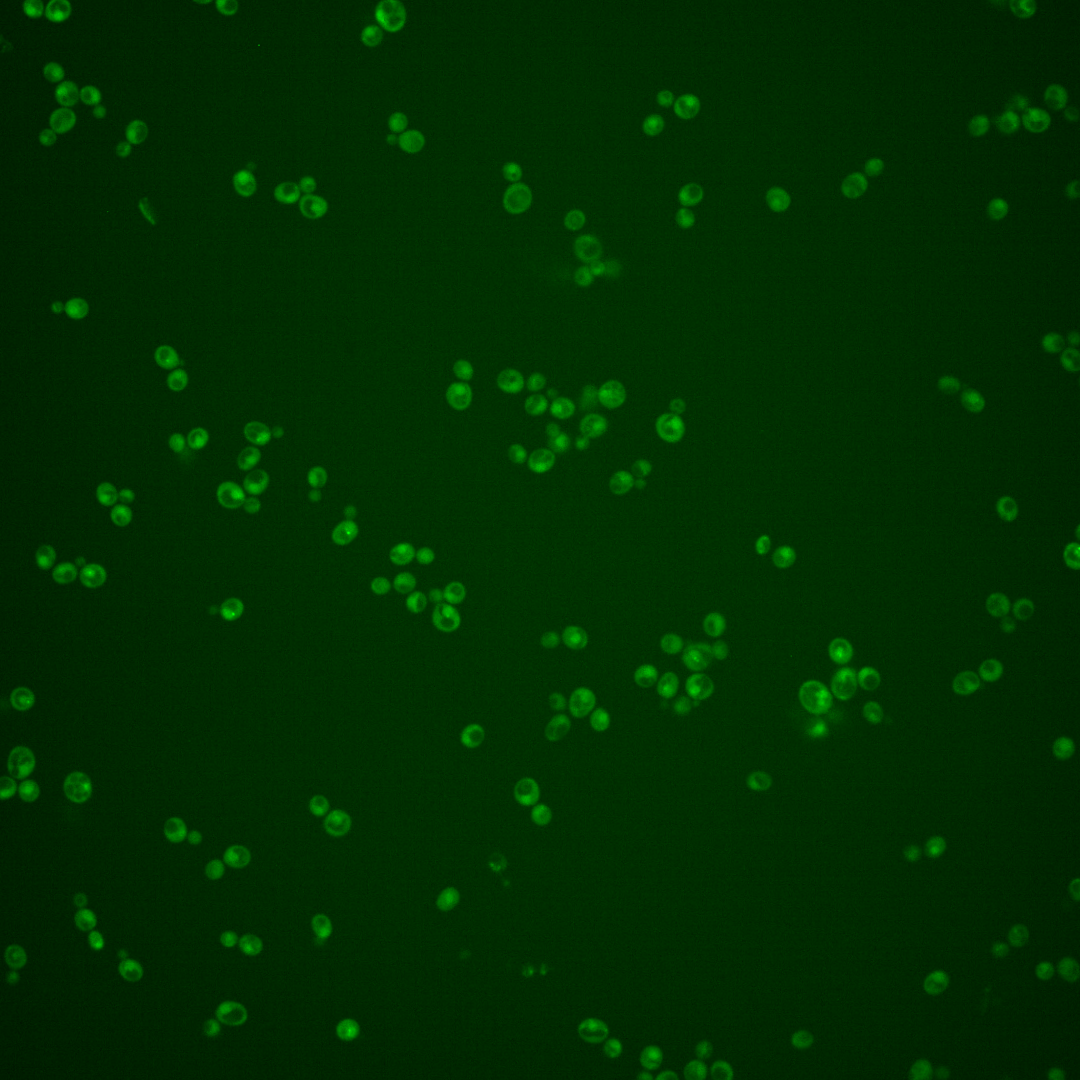
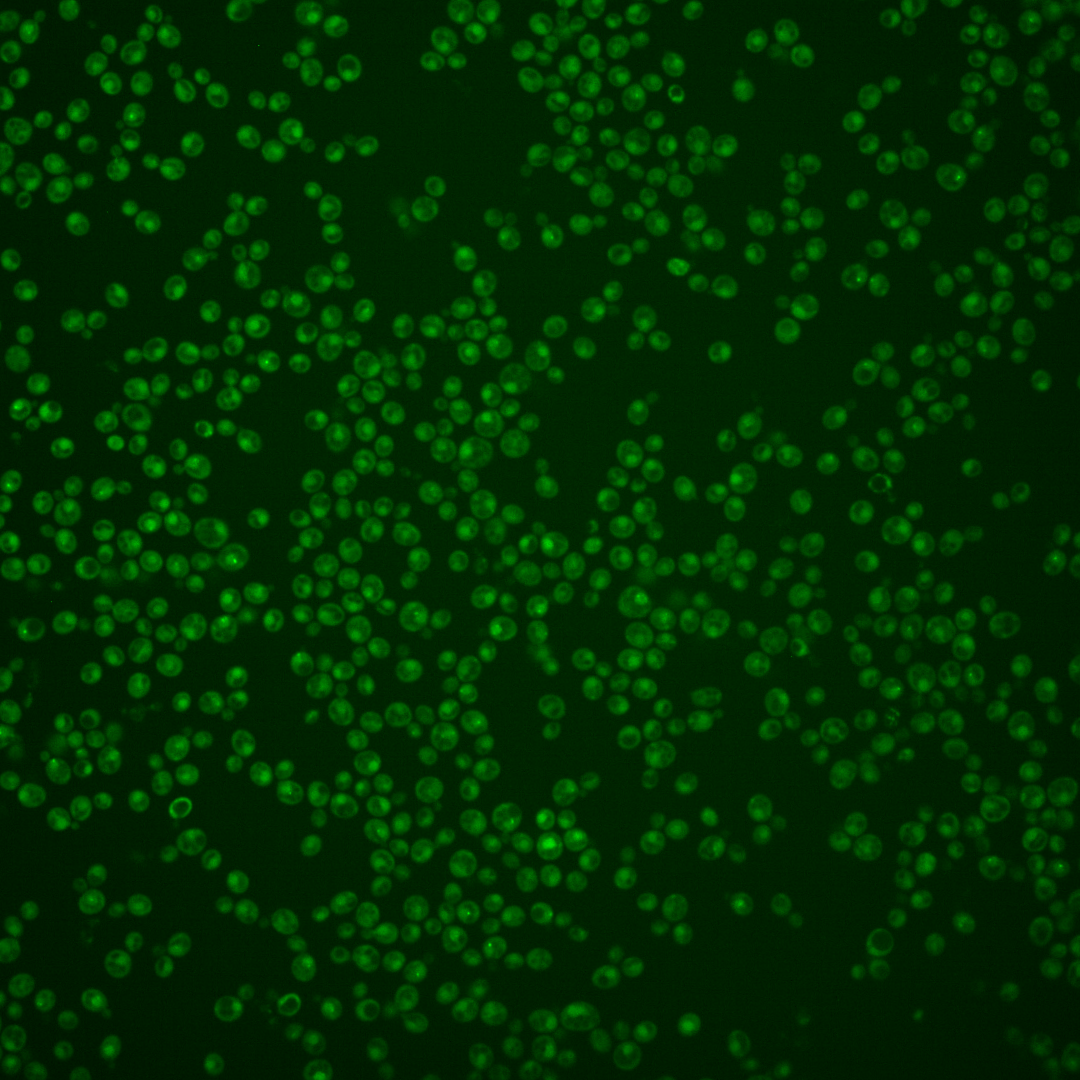
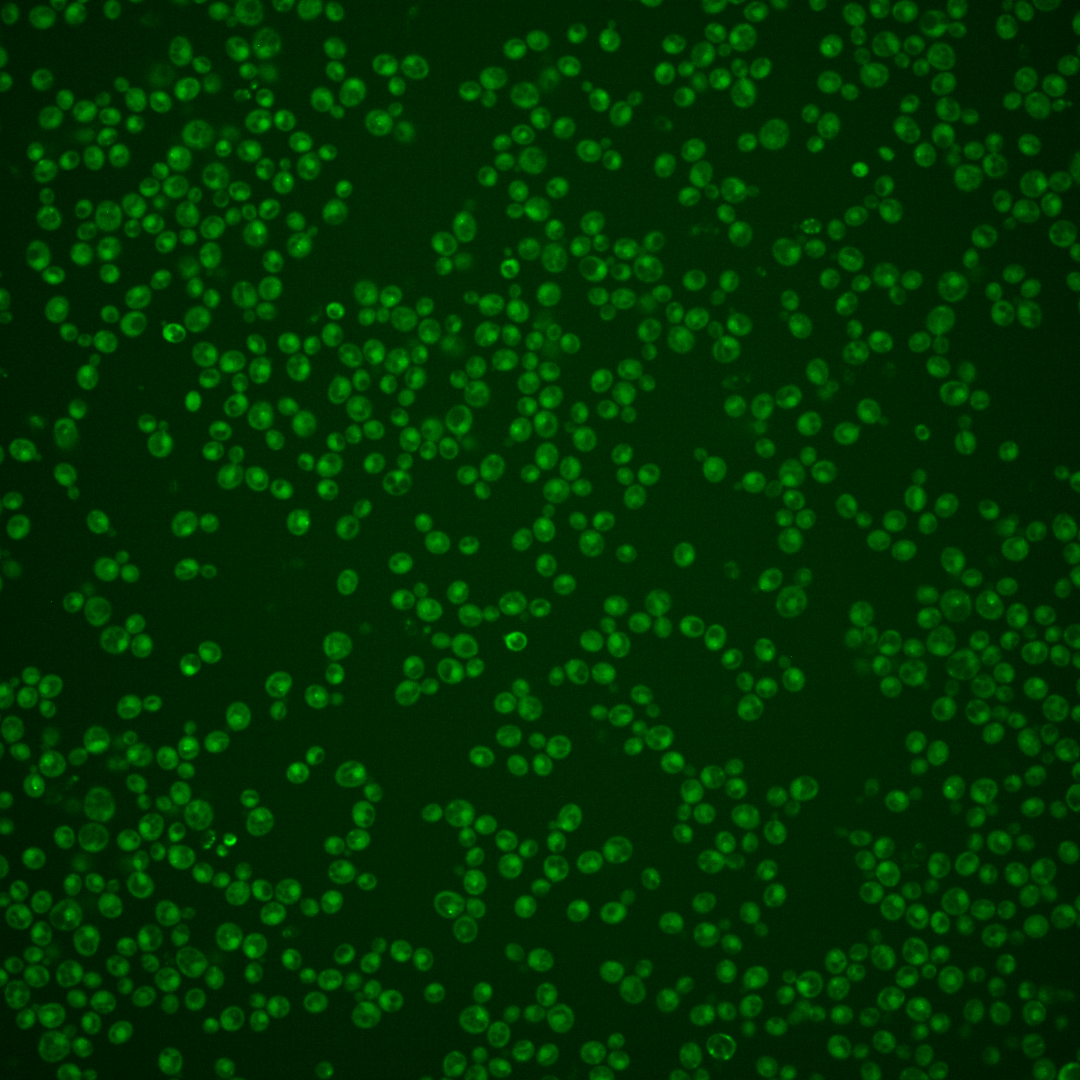
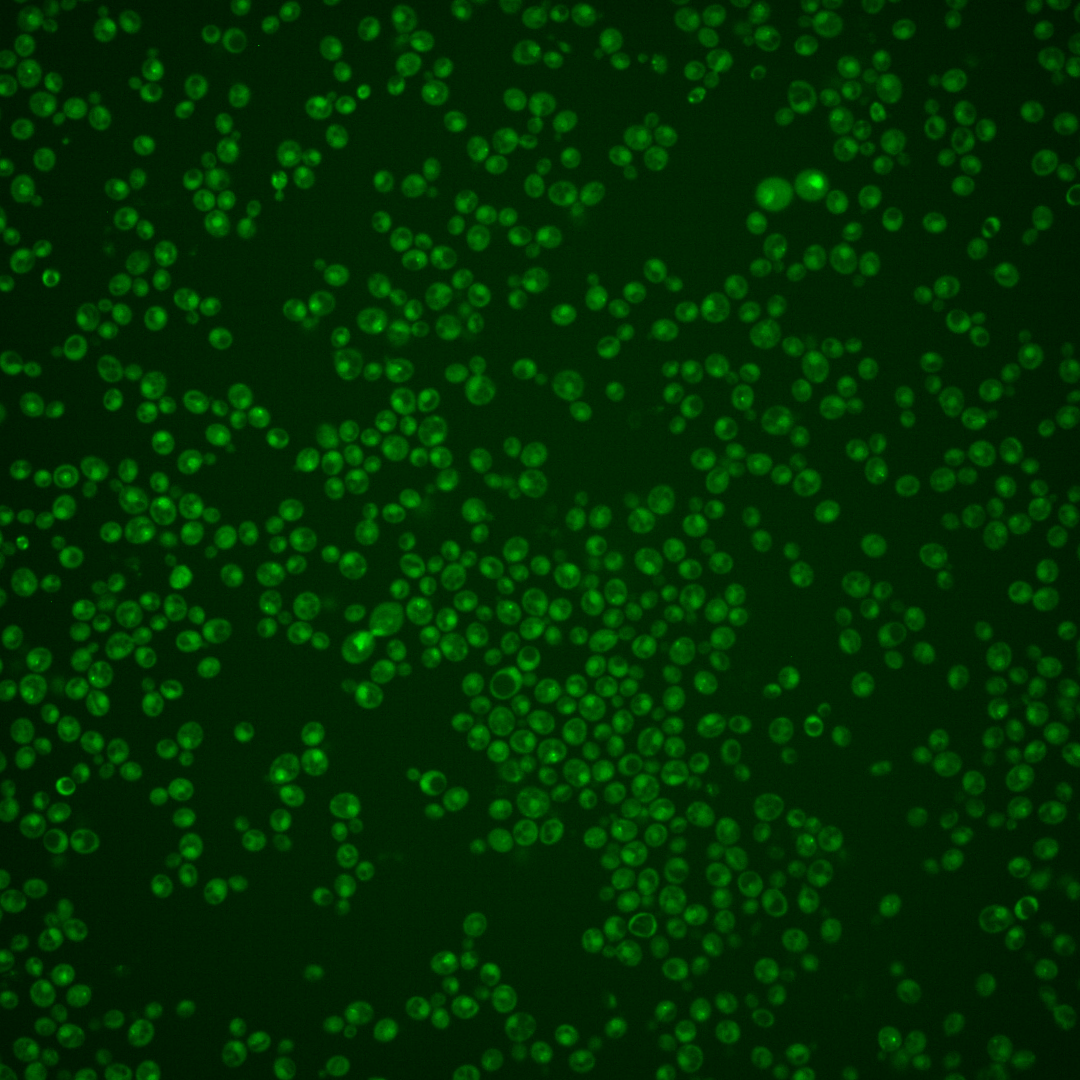

| Standard name | |
|---|---|
| Human Ortholog | |
| Description | Endonuclease involved in processing DNA; acts during recombination, repair; promotes template switching during break-induced replication (BIR), causing non-reciprocal translocations (NRTs); cleaves branched structures in complex with Slx1p; involved in interstrand cross-link repair, Rad1p/Rad10p-dependent removal of 3'-nonhomologous tails during DSBR via single-strand annealing; relative distribution to nuclear foci increases upon DNA replication stress; FANCP-related factor |
Micrographs




















































































Sub-cellular Localization
Yeast GFP Assignment
Protein Abundance
Localization Change
External localization resources
| ensLOC | DeepLoc | |||||||||||||||||||||||
|---|---|---|---|---|---|---|---|---|---|---|---|---|---|---|---|---|---|---|---|---|---|---|---|---|
| Localization | WT1 | WT2 | WT3 | RAP60 | RAP140 | RAP220 | RAP300 | RAP380 | RAP460 | RAP540 | RAP620 | RAP700 | HU80 | HU120 | HU160 | rpd3Δ_1 | rpd3Δ_2 | rpd3Δ_3 | WT1 | WT2 | WT3 | AF100 | AF140 | AF180 |
| Cortical Patches | 0 | 0 | 2 | 1 | 3 | 0 | 0 | – | 0 | 0 | 1 | 0 | 0 | 0 | 0 | 0 | 0 | 0 | 1 | 3 | 2 | 1 | 5 | 7 |
| Bud | 0 | 0 | 2 | 6 | 4 | 5 | 6 | – | 11 | 7 | 8 | 11 | 6 | 1 | 0 | 0 | 0 | 0 | 1 | 2 | 3 | 5 | 6 | 11 |
| Bud Neck | 0 | 0 | 12 | 6 | 28 | 12 | 13 | – | 4 | 4 | 10 | 8 | 0 | 0 | 0 | 1 | 0 | 0 | 0 | 3 | 2 | 3 | 3 | 9 |
| Bud Site | 0 | 0 | 0 | 0 | 2 | 5 | 0 | – | 5 | 6 | 12 | 9 | 3 | 0 | 0 | 0 | 0 | 0 | – | – | – | – | – | – |
| Cell Periphery | 0 | 0 | 0 | 1 | 0 | 0 | 0 | – | 0 | 1 | 0 | 2 | 0 | 0 | 0 | 0 | 0 | 0 | 0 | 0 | 0 | 0 | 1 | 2 |
| Cytoplasm | 77 | 94 | 191 | 133 | 142 | 197 | 279 | – | 176 | 232 | 158 | 185 | 165 | 249 | 278 | 89 | 43 | 24 | 64 | 61 | 104 | 110 | 167 | 324 |
| Endoplasmic Reticulum | 3 | 1 | 0 | 0 | 3 | 0 | 1 | – | 0 | 0 | 0 | 1 | 2 | 2 | 1 | 9 | 6 | 3 | 2 | 1 | 2 | 4 | 5 | 5 |
| Endosome | 2 | 11 | 1 | 6 | 8 | 15 | 3 | – | 1 | 2 | 1 | 26 | 13 | 43 | 15 | 20 | 13 | 6 | 15 | 11 | 8 | 9 | 8 | 5 |
| Golgi | 0 | 0 | 0 | 0 | 0 | 0 | 0 | – | 0 | 0 | 0 | 0 | 0 | 0 | 0 | 2 | 0 | 0 | 0 | 0 | 0 | 1 | 0 | 2 |
| Mitochondria | 40 | 34 | 0 | 30 | 18 | 98 | 141 | – | 247 | 257 | 213 | 150 | 110 | 45 | 50 | 15 | 2 | 1 | 19 | 16 | 32 | 42 | 60 | 76 |
| Nucleus | 10 | 19 | 7 | 20 | 10 | 24 | 37 | – | 38 | 58 | 34 | 34 | 70 | 38 | 41 | 17 | 16 | 14 | 22 | 39 | 27 | 27 | 16 | 11 |
| Nuclear Periphery | 0 | 0 | 0 | 0 | 0 | 0 | 0 | – | 2 | 0 | 0 | 1 | 0 | 0 | 2 | 0 | 0 | 0 | 2 | 1 | 0 | 0 | 0 | 0 |
| Nucleolus | 0 | 0 | 0 | 2 | 1 | 2 | 0 | – | 4 | 4 | 2 | 0 | 6 | 4 | 1 | 4 | 3 | 1 | 0 | 2 | 3 | 1 | 0 | 0 |
| Peroxisomes | 0 | 0 | 0 | 1 | 0 | 1 | 0 | – | 0 | 0 | 0 | 0 | 0 | 0 | 0 | 0 | 0 | 0 | 0 | 0 | 0 | 0 | 0 | 0 |
| SpindlePole | 6 | 8 | 16 | 27 | 76 | 42 | 40 | – | 21 | 32 | 24 | 30 | 6 | 9 | 2 | 7 | 5 | 3 | 22 | 32 | 52 | 17 | 17 | 13 |
| Vac/Vac Membrane | 37 | 57 | 24 | 8 | 22 | 27 | 25 | – | 23 | 23 | 24 | 33 | 78 | 106 | 82 | 77 | 50 | 21 | 43 | 68 | 70 | 132 | 158 | 151 |
| Unique Cell Count | 152 | 195 | 238 | 204 | 278 | 359 | 478 | 428 | 520 | 388 | 414 | 407 | 449 | 436 | 197 | 115 | 61 | 207 | 250 | 328 | 364 | 463 | 638 | |
| Labelled Cell Count | 175 | 224 | 255 | 241 | 317 | 428 | 545 | 532 | 626 | 487 | 490 | 459 | 497 | 472 | 241 | 138 | 73 | 207 | 250 | 328 | 364 | 463 | 638 | |
Yeast GFP Assignment
Protein Abundance
| Screen | WT1 | WT2 | WT3 | RAP60 | RAP140 | RAP220 | RAP300 | RAP380 | RAP460 | RAP540 | RAP620 | RAP700 | HU80 | HU120 | HU160 | rpd3Δ_1 | rpd3Δ_2 | rpd3Δ_3 | AF100 | AF140 | AF180 |
|---|---|---|---|---|---|---|---|---|---|---|---|---|---|---|---|---|---|---|---|---|---|
| Mean Cell GFP Intensity (1e-4) | 3.8 | 3.8 | 4.8 | 4.1 | 4.8 | 3.8 | 3.9 | – | 3.4 | 3.4 | 3.2 | 3.9 | 3.8 | 3.8 | 4.0 | 5.8 | 6.0 | 5.9 | 3.7 | 3.8 | 4.0 |
| Std Deviation (1e-4) | 0.6 | 0.7 | 1.2 | 1.0 | 1.3 | 1.2 | 0.9 | – | 1.1 | 1.1 | 1.0 | 0.9 | 0.7 | 1.0 | 0.8 | 1.1 | 1.0 | 0.9 | 0.9 | 1.2 | 1.2 |
| Intensity Change (Log2) | – | – | – | -0.23 | -0.0 | -0.34 | -0.31 | – | -0.47 | -0.48 | -0.57 | -0.29 | -0.33 | -0.31 | -0.27 | 0.29 | 0.33 | 0.3 | -0.36 | -0.33 | -0.27 |
Localization Change
| Localization | RAP60 | RAP140 | RAP220 | RAP300 | RAP380 | RAP460 | RAP540 | RAP620 | RAP700 | HU80 | HU120 | HU160 | rpd3Δ_1 | rpd3Δ_2 | rpd3Δ_3 |
|---|---|---|---|---|---|---|---|---|---|---|---|---|---|---|---|
| Actin | – | – | – | – | – | – | – | – | – | – | – | – | – | – | – |
| Bud | – | – | – | – | – | – | – | – | – | – | – | – | 0 | 0 | 0 |
| Bud Neck | – | – | – | – | – | – | – | – | – | – | – | – | 0 | 0 | 0 |
| Bud Site | – | – | – | – | – | – | – | – | – | – | – | – | 0 | 0 | 0 |
| Cell Periphery | – | – | – | – | – | – | – | – | – | – | – | – | 0 | 0 | 0 |
| Cyto | – | – | – | – | – | – | – | – | – | – | – | – | – | – | – |
| Endoplasmic Reticulum | – | – | – | – | – | – | – | – | – | – | – | – | 0 | 0 | 0 |
| Endosome | – | – | – | – | – | – | – | – | – | – | – | – | 0 | 0 | 0 |
| Golgi | – | – | – | – | – | – | – | – | – | – | – | – | 0 | 0 | 0 |
| Mitochondria | – | – | – | – | – | – | – | – | – | – | – | – | 0 | 0 | 0 |
| Nuclear Periphery | – | – | – | – | – | – | – | – | – | – | – | – | 0 | 0 | 0 |
| Nuc | – | – | – | – | – | – | – | – | – | – | – | – | – | – | – |
| Nucleolus | – | – | – | – | – | – | – | – | – | – | – | – | 0 | 0 | 0 |
| Peroxisomes | – | – | – | – | – | – | – | – | – | – | – | – | 0 | 0 | 0 |
| SpindlePole | – | – | – | – | – | – | – | – | – | – | – | – | 0 | 0 | 0 |
| Vac | – | – | – | – | – | – | – | – | – | – | – | – | – | – | – |
| Cortical Patches | – | – | – | – | – | – | – | – | – | – | – | – | 0 | 0 | 0 |
| Cytoplasm | – | – | – | – | – | – | – | – | – | – | – | – | 0 | 0 | 0 |
| Nucleus | – | – | – | – | – | – | – | – | – | – | – | – | 0 | 0 | 0 |
| Vacuole | – | – | – | – | – | – | – | – | – | – | – | – | 7.1 | 7.2 | 4.7 |
External localization resources
Images






























Protein Concentration and Protein Localization Data
| R1 | R2 | R3 | ||||||||||||||||
|---|---|---|---|---|---|---|---|---|---|---|---|---|---|---|---|---|---|---|
| G1 Pre-START | G1 Post-START | S/G2 | Metaphase | Anaphase | Telophase | G1 Pre-START | G1 Post-START | S/G2 | Metaphase | Anaphase | Telophase | G1 Pre-START | G1 Post-START | S/G2 | Metaphase | Anaphase | Telophase | |
| Concentration | 0.5113 | -0.9421 | -0.3618 | -0.0836 | 0.7351 | -0.9331 | -0.9205 | -0.8137 | -0.7188 | -0.8825 | -0.5728 | -0.8295 | -0.6988 | -0.5866 | -0.6879 | -0.8559 | -0.8383 | -0.9902 |
| Actin | 0.0302 | 0.0005 | 0.0386 | 0.0137 | 0.0019 | 0.0007 | 0.0132 | 0.0007 | 0.0268 | 0.0056 | 0.0026 | 0.0037 | 0.0334 | 0.0012 | 0.0021 | 0.0221 | 0.0065 | 0.0002 |
| Bud | 0.0004 | 0.0001 | 0.0006 | 0.0004 | 0.0002 | 0.0001 | 0.0015 | 0.0006 | 0.0004 | 0.0002 | 0.0003 | 0.0008 | 0.0005 | 0.0017 | 0.0012 | 0.0003 | 0.0001 | 0.0001 |
| Bud Neck | 0.0065 | 0.0005 | 0.0017 | 0.0029 | 0.0005 | 0.0017 | 0.0041 | 0.0004 | 0.0011 | 0.001 | 0.0014 | 0.0035 | 0.0103 | 0.0002 | 0.0017 | 0.0004 | 0.0007 | 0.0013 |
| Bud Periphery | 0.0006 | 0.0002 | 0.0006 | 0.0009 | 0.0002 | 0.0002 | 0.0021 | 0.0009 | 0.0017 | 0.0003 | 0.0004 | 0.0008 | 0.0007 | 0.0004 | 0.0013 | 0.0007 | 0.0002 | 0 |
| Bud Site | 0.0036 | 0.0014 | 0.0109 | 0.0028 | 0.0002 | 0.0003 | 0.0175 | 0.005 | 0.0015 | 0.001 | 0.0007 | 0.0006 | 0.015 | 0.0043 | 0.0019 | 0.0003 | 0.0002 | 0.0001 |
| Cell Periphery | 0.0004 | 0.0002 | 0.0003 | 0.0007 | 0.0001 | 0 | 0.0008 | 0.0002 | 0.0001 | 0.0001 | 0.0001 | 0.0002 | 0.0007 | 0.0001 | 0.0002 | 0.0001 | 0 | 0 |
| Cytoplasm | 0.0885 | 0.1356 | 0.1981 | 0.063 | 0.048 | 0.1485 | 0.1656 | 0.1274 | 0.1059 | 0.1359 | 0.1053 | 0.211 | 0.2013 | 0.2138 | 0.2035 | 0.0972 | 0.1683 | 0.2828 |
| Cytoplasmic Foci | 0.063 | 0.0201 | 0.0307 | 0.0282 | 0.0367 | 0.0168 | 0.027 | 0.0152 | 0.032 | 0.023 | 0.0403 | 0.0109 | 0.0746 | 0.0219 | 0.0329 | 0.0034 | 0.0052 | 0.0057 |
| Eisosomes | 0.0004 | 0.0002 | 0.0004 | 0.001 | 0.0001 | 0.0001 | 0.0002 | 0.0001 | 0.0003 | 0.0001 | 0.0001 | 0.0001 | 0.0009 | 0.0002 | 0.0001 | 0.0002 | 0.0001 | 0.0001 |
| Endoplasmic Reticulum | 0.0097 | 0.0053 | 0.0142 | 0.0033 | 0.0032 | 0.0022 | 0.0057 | 0.0041 | 0.0042 | 0.0036 | 0.0024 | 0.0034 | 0.0067 | 0.0028 | 0.0078 | 0.0103 | 0.0052 | 0.0023 |
| Endosome | 0.0449 | 0.0042 | 0.0383 | 0.075 | 0.111 | 0.0036 | 0.0287 | 0.0093 | 0.0129 | 0.0083 | 0.0564 | 0.0062 | 0.029 | 0.0058 | 0.0214 | 0.0037 | 0.0377 | 0.0052 |
| Golgi | 0.0081 | 0.0002 | 0.0108 | 0.0298 | 0.0655 | 0.0008 | 0.0084 | 0.0003 | 0.0071 | 0.0007 | 0.0156 | 0.0003 | 0.0062 | 0.0011 | 0.0016 | 0.001 | 0.003 | 0.0002 |
| Lipid Particles | 0.0315 | 0.0108 | 0.0054 | 0.1126 | 0.0045 | 0.007 | 0.0185 | 0.0021 | 0.0204 | 0.0018 | 0.0251 | 0.0012 | 0.0147 | 0.0054 | 0.0031 | 0.001 | 0.003 | 0.0014 |
| Mitochondria | 0.0054 | 0.0005 | 0.0072 | 0.0257 | 0.0139 | 0.001 | 0.0069 | 0.0008 | 0.0134 | 0.0014 | 0.0102 | 0.0094 | 0.003 | 0.0005 | 0.002 | 0.0008 | 0.0021 | 0.0004 |
| None | 0.432 | 0.6713 | 0.3066 | 0.409 | 0.4799 | 0.6396 | 0.3496 | 0.615 | 0.354 | 0.3645 | 0.2581 | 0.3283 | 0.2809 | 0.5617 | 0.4158 | 0.5194 | 0.6313 | 0.346 |
| Nuclear Periphery | 0.0556 | 0.0064 | 0.0304 | 0.0073 | 0.1231 | 0.0075 | 0.0353 | 0.0177 | 0.0303 | 0.0205 | 0.0129 | 0.0129 | 0.0321 | 0.0063 | 0.0203 | 0.0089 | 0.0294 | 0.0176 |
| Nucleolus | 0.0038 | 0.0049 | 0.0074 | 0.0079 | 0.001 | 0.004 | 0.0068 | 0.0061 | 0.0071 | 0.0168 | 0.0057 | 0.0051 | 0.0036 | 0.0016 | 0.0167 | 0.0063 | 0.0008 | 0.0023 |
| Nucleus | 0.139 | 0.1001 | 0.2125 | 0.1789 | 0.069 | 0.1308 | 0.2266 | 0.1495 | 0.2366 | 0.3051 | 0.2884 | 0.3291 | 0.225 | 0.1263 | 0.1449 | 0.3021 | 0.0942 | 0.2621 |
| Peroxisomes | 0.0192 | 0.0004 | 0.002 | 0.008 | 0.0006 | 0.0066 | 0.0139 | 0.0004 | 0.0113 | 0.0038 | 0.048 | 0.0004 | 0.0102 | 0.0022 | 0.0012 | 0.0002 | 0.0006 | 0.0001 |
| Punctate Nuclear | 0.0499 | 0.0345 | 0.0775 | 0.0137 | 0.0305 | 0.0273 | 0.0545 | 0.0383 | 0.1296 | 0.1033 | 0.1199 | 0.069 | 0.0462 | 0.04 | 0.1077 | 0.02 | 0.0076 | 0.0701 |
| Vacuole | 0.0046 | 0.0024 | 0.0045 | 0.0113 | 0.0042 | 0.001 | 0.0098 | 0.005 | 0.0022 | 0.0025 | 0.0037 | 0.0025 | 0.0036 | 0.0021 | 0.0101 | 0.0012 | 0.0019 | 0.0016 |
| Vacuole Periphery | 0.0028 | 0.0003 | 0.001 | 0.0038 | 0.0059 | 0.0002 | 0.0032 | 0.001 | 0.001 | 0.0007 | 0.0024 | 0.0006 | 0.0014 | 0.0003 | 0.0025 | 0.0004 | 0.002 | 0.0003 |
Sequencing Data
| R1 | R2 | |||||||||
|---|---|---|---|---|---|---|---|---|---|---|
| G1 Post-START | S/G2 | Metaphase | Anaphase | Telophase | G1 Post-START | S/G2 | Metaphase | Anaphase | Telophase | |
| Gene Expression | 9.3301 | 1.7559 | 1.303 | 4.1029 | 10.1868 | 8.8341 | 5.77 | 5.9913 | 4.0657 | 7.1794 |
| Translational Efficiency | – | – | – | – | – | – | – | – | – | – |
Hit Data
| Dataset | Hit |
|---|---|
| Protein Concentration | ✘ |
| Protein Localization | ✘ |
| Gene Expression | ✘ |
| Translational Efficiency | – |
Endocytosis
| Temp | Actin Patch (Sac6-tdTomato) | Cortical Patch (Sla1-GFP) | Late Endosome (Snf7-GFP) | Vacuole (Vph1-GFP) |
|---|---|---|---|---|
| 37℃ | ||||
| RT |
Cell Cycle Omics
CYCLoPs (Slx4-GFP)
| Gene / Allele | Actin Patch (Sac6-tdTomato) | Cortical Patch (Sla1-GFP) | Late Endosome (Snf7-GFP) | Vacuole (Sac6-tdTomato) |
|---|
| Gene | Images |
|---|
| Gene | Images |
|---|
Images are not yet available
Images are not yet available